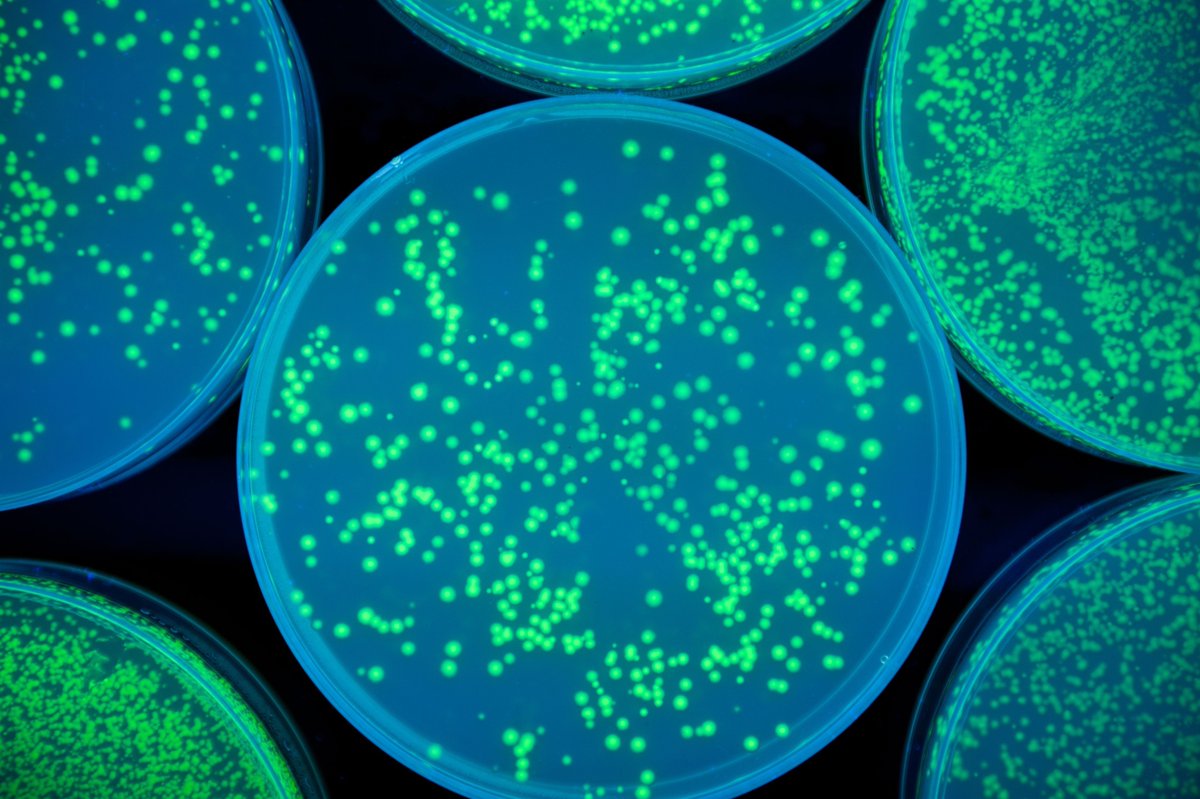
litegrav tweet media

Adam Alonzi retweetledi

Two weeks ago, I met @Adam_Alonzi at a coffee shop. We started talking about crypto and I told him about $KAS saw him at the same spot today he told me he bought some and wrote an article about it. This is how the community grows. #Kaspa #KAS
@tradingtableaus/the-whales-in-the-room-on-being-bullish-on-kaspa-and-the-virtue-of-being-two-months-early-fece535823ee" target="_blank" rel="nofollow noopener">medium.com/@tradingtablea…
English